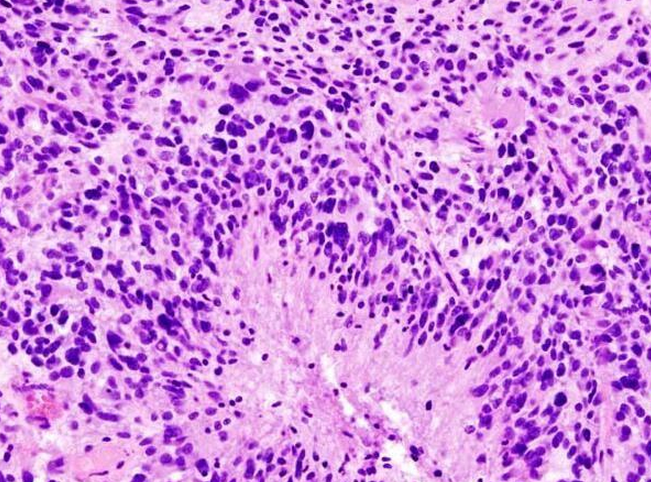

研发追踪
研发追踪
 2017-05-23
2017-05-23
 7203
7203
来源:生物谷 2017-05-23
近日,来自美国西北大学的研究人员通过研究利用球形核酸开发出了首个能够用于人类机体全身性治疗的药物,目前这种球形核酸药物已经获得FDA批准,并且作为一种试验性新药正在处于多形性胶质母细胞瘤的早期临床试验中。
这种新药能够跨越血脑屏障直接进入动物模型大脑的肿瘤患处,在肿瘤位点该药物能够关闭关键的促癌基因的表达,目前正在进行的0期临床试验就在调查该药物是否能够直接到达人类机体的肿瘤位点。治疗胶质母细胞瘤的药物代表了一类革命性的新型药物,研究者表示,这种新型的球形核酸平台还能够用于对其它神经变性疾病进行研究,比如阿尔兹海默病和帕金森疾病,其能够通过类似的作用机制来关闭诱发多种神经变性疾病的基因的表达。

美国西北大学的副校长Jay Walsh表示,我们想尽可能快地让这种新药进入人类机体临床试验,同时我们还会继续推动这种新药的研究,因为目前胶质母细胞瘤患者并没有有效的疗法。在批准进入临床环境使用之前,这种名为NU-0129的药物还需要经过很多个阶段的审查。研究者Alexander Stegh教授说道,我们知道这种药物能够在小鼠机体中发挥作用,如今我们还想知道,是否该药物能够跨越人类机体的血脑屏障,并且在患者机体肿瘤位点进行积累,如果球形核酸药物能够跨越血脑屏障并且在大脑中积累,那么其未来的应用或许并不仅仅是治疗胶质母细胞瘤了,研究人员或许还能够通过八项作用和其它多种疾病相关的通路来靶向治疗其它大脑疾病,比如亨廷顿氏症、帕金森疾病以及阿尔兹海默病。
这种新药由多个短片段的RNA密集地排列在球形纳米颗粒表面组成,其能够改变肿瘤细胞的遗传组成成分并且减缓肿瘤细胞分裂的能力,而且该药物还能够靶向作用参与细胞凋亡或程序性细胞死亡的关键基因BCL2L12。研究者Mirkin及其团队开发了球形核酸,Stegh等人鉴别出了能够靶向作用的核酸。
通常研究人员利用化疗、放疗和外科手术的方法来治疗胶质母细胞瘤患者,但针对该疾病目前并没有有效的治愈手段,在美国每年大约30000名个体会被诊断为恶性脑癌,而且患者的预期寿命仅为14-16个月。研究者Priya Kumthekar教授说道,我们迫切需要一种能够治疗这种恶性疾病的有效疗法,这项研究中,我们招募了肿瘤复发的患者以及肿瘤移除的候选者进行研究,在患者进行外科手术之前首先通过静脉注射这种新型药物,当肿瘤被移除后,我们将会对肿瘤的药物成分进行研究确定这种新型药物是否能够有效跨越患者的血脑屏障对肿瘤实施精准打击。
基于动物模型试验,研究者发现这种药物能够很好地渗透到肿瘤位点,这样研究者就能够有效预测药物的作用效率了;Lurie癌症研究中心的主任Leon Platanias说道,这种首个用于人类临床试验的球形核酸技术具有非常强大的效力,而且还能够帮助我们开发出新型有效治疗脑瘤的疗法,当然未来其或许还有望帮助治疗其它人类肿瘤。
这种药物的问世就是球形纳米颗粒和遗传学的完美结合;从2009年开始,研究者Stegh和Mirkin就通过合作克服重重困难开发治疗胶质母细胞瘤的新型疗法,Mirkin有着非常完美的工具:球形核酸,其是DNA和RNA的新型球形形式,而且对人类机体无毒性,同时核酸序列还能够与靶向基因所匹配;2007年,研究者Stegh及其同事通过研究发现,基因BCL2L12在胶质母细胞瘤肿瘤中会发生过表达,而且其还介导了胶质母细胞瘤对常规疗法的耐药性。
这种新型疗法如何工作?
由于具有新型结构,这种新型的治疗手段实际上能够积极对跨越血脑屏障,从而就能够到达大脑肿瘤位点,一旦进入癌细胞,这种药物就能够沉默诱发疾病的基因的表达,RNA的程序性序列能够扮演一种变光开关的角色。其能够选择性地阻止细胞产生和疾病相关的特殊蛋白质,最终的结果就是诱发癌细胞死亡,并且抑制细胞生长。
这种新型药物成功的关键就在于其具有纳米3-D球形结构以及核酸的密度,正常的线性核酸无法进入细胞或者跨越血脑屏障,但这种球形核酸就可以实现上述过程,RNA链能够吸附并且像保护壳一样围绕在金纳米颗粒上,核酸能够被密集性地包裹并且形成微型的球体结构,而且这种金纳米颗粒的核心的直径仅有13纳米。
关键性的动物研究
2013年,研究者Stegh和Mirkin就通过联合研究在Science Translational Medicine杂志上发表了他们的研究成果,他们首次描述了利用静脉注射运输药物可以关闭胶质母细胞瘤中关键的促癌基因,同时还能够降低肿瘤的进展,明显增加患病小鼠的生存率。在患胶质母细胞瘤的小鼠机体中,大约1%的注射剂量药物就能够有效在颅内大脑肿瘤组织中积累,更有意思的是,这种新型的球形核酸还能够选择性在肿瘤位点进行积累,这很有可能是由于肿瘤能够产生渗漏的血管,使纳米颗粒具有能够仅在肿瘤组织中积累的能力。
相比对照组小鼠而言,接受新型疗法治疗的动物模型的生存率能够增加大约20%,而且肿瘤尺寸也会明显下降3-4倍。研究者Mirkin在1996年首次通过研究开发出了这种纳米平台,同时研究者们也首次意识到将这种纳米结构注射到动物模型体内能够帮助寻找大脑中的肿瘤靶点,并且将有效的药物运输到肿瘤位点实施精准打击。未来研究者们还将通过更为深入的联合研究来检测这种新型的球形核酸药物在治疗多种脑瘤中的作用效力

 研发追踪
研发追踪
 医药观澜
医药观澜  2026-06-30
2026-06-30
 337
337

 研发追踪
研发追踪
 思宇MedTech
思宇MedTech  2026-06-30
2026-06-30
 367
367

 研发追踪
研发追踪
 药渡
药渡  2026-06-30
2026-06-30
 353
353
 热门资讯
热门资讯